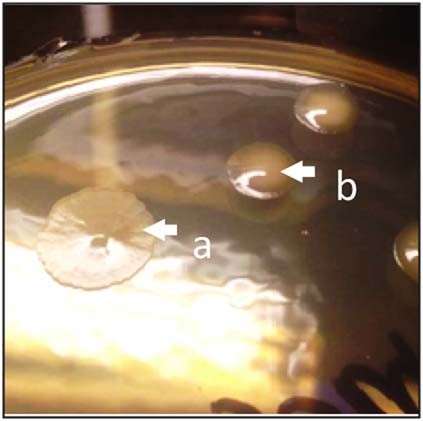
Extended Data Fig. 3: Morphotype of the oxygen adapted F. prausnitzii DSM 32379.

Extended Data Fig. 3: Morphotype of the oxygen adapted F. prausnitzii DSM 32379.
From: Synergy and oxygen adaptation for development of next-generation probiotics
Morphotype of F. prausnitzii DSM 32379 (arrow b) isolated from m-SHIRM bioreactor during the 10th subculture step. The parental strain F. prausnitzii DSM 32186 is shown as reference (arrow a).